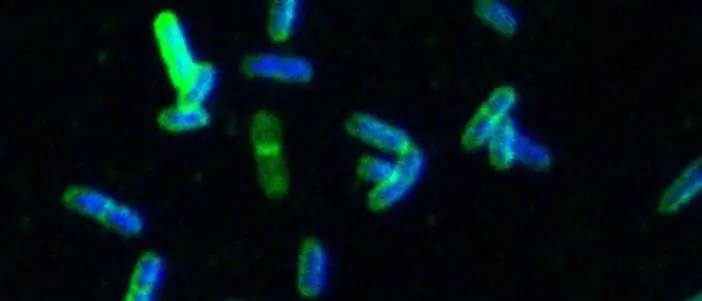
Image

Сахарный зонтик защищает бактерии
Вирус HI извлекает выгоду из полного разрушения иммунной системы: он в основном заражает и разрушает Т-хелперные клетки, которые выполняют центральную функцию в защите организма. В здоровом организме они обычно предупреждают другие иммунные клетки о вторжении патогенов, высвобождая цитокины в качестве сигнала тревоги. Однако у ВИЧ-инфицированных людей важная функция усилителя постепенно исчезает с уменьшением количества Т-хелперов. Поэтому те, кто пострадал, все чаще страдают от вторичных инфекций, которые здоровая иммунная система может контролировать.
В течение долгого времени, однако, исследователи задавались вопросом, почему бактерии, родственные возбудителю сыпного тифа, известные как нетифозная кишечная сальмонелла, особенно сильно поражают пациентов с ВИЧ - эта группа возбудителей представляет собой одну из самых опасных угроз. к СПИДу, особенно в более бедных странах. Международная группа исследователей пришла к удивительному ответу: иммунная система, инфильтрированная ВИЧ, довольно жестко атакует эти виды сальмонелл, но безуспешно в тот момент, когда беспомощные иммунные войска встают на пути более эффективных атак.
Ахиллесова пята бактерий
Некоторое время назад исследователи СПИДа сделали простой обратный вывод из того факта, что хронически инфицированные ВИЧ люди со временем все больше и больше страдают от таких бактерий, как сальмонелла: потому что ВИЧ особенно поражает клеточно-опосредованную ветвь иммунной системы. с его Т-клетками должны иметь особое значение в борьбе с сальмонеллой. Однако теперь ясно, что этого было недостаточно: второе, основанное на антителах, звено иммунной системы также вносит значительный вклад в борьбу с сальмонеллой и т.п., как показали исследования..
Calman MacLennan из Университета Бирмингема в Англии и его коллеги поэтому предположили, что все пациенты с ВИЧ, страдающие от сальмонеллы, просто больше не вырабатывают антитела против бактерии. Теперь они просто хотели выяснить, каким образом ВИЧ также парализует выработку антител в организме. Однако уже во время первых исследований исследователей ждал сюрприз: на самом деле они обнаружили антитела против бактерии в крови ВИЧ-инфицированных людей, которых также атаковала сальмонелла, причем в удивительно большом количестве. Однако, по-видимому, эти антитела бесполезны для пораженных: бактерии выживают в крови, хотя и помечаются антителами как враждебные.
Захватчики, стигматизированные антителами, обычно уничтожаются в организме так называемой системой комплемента, но исследователи показали, что она также прекрасно функционировала у исследованных пациентов. Таким образом, все эффективные защитные механизмы организма готовы к использованию, но почему отмеченные микробы сальмонеллы до сих пор не уничтожены?
Сахарные цепи как лопасти ветряной мельницы
Понадобилась целая серия экспериментов, чтобы пролить свет на тьму. Во-первых, команда Макленнана определила, что сальмонеллы в первую очередь уничтожаются антителами, которые связываются со специфическими белками пориновых каналов в наружной мембране бактерий. Эти антитела были обнаружены и в крови ВИЧ-инфицированных - но, видимо, они даже не попали туда, где были нужны. Вторая группа антител, как ни странно, в больших количествах вырабатываемых ВИЧ-инфицированными, блокирует им путь: большое их количество связывается с длинными сахаро-липидными цепями, выступающими из бактериальной оболочки подобно лесу антенн. После прикрепления антитела, по-видимому, образуют барьер, который предотвращает доступ других защитных молекул к бактериальной поверхности: только когда исследователи отрезали сахарные липидные цепи сальмонелл ферментными ножницами, поврежденная ВИЧ защитная система смогла достичь микробов. снова - и убить их.

Единственный вопрос, который остается, заключается в том, как инфицирование Т-хелперов вирусом HI приводит к тому, что другая ветвь иммунной системы, которая фактически ослаблена в целом, а именно выработка антител против бактерий, внезапно стимулируется к массово производить неэффективные антитела против липидных цепей сахара, а затем использовать их, чтобы помешать эффективной борьбе с вторичными инфекциями.
Возможно, МакЛеннан и его коллеги предполагают, что ВИЧ вызывает циркуляцию большего количества фрагментов сахарных липидных цепей в крови пострадавших, что затем стимулирует иммунную систему вырабатывать массивную армаду антител, хотя и пытались, но неэффективен в целом. Такие липиды-сахара могут поступать из слизистой оболочки пищеварительного тракта, которая сильно поражается в ходе вирусной инфекции. Однако первые анализы этого не подтверждают: повышенного количества липополисахаридных цепочек в крови инфицированных нет. Так что поиски должны продолжаться. Тем не менее выводы МакКленнана и его коллег должны помочь избежать крупной ошибки при разработке вакцин против сальмонеллы - в качестве мишеней следует выбирать мембранные белки, а не сахарные липидные цепи.
